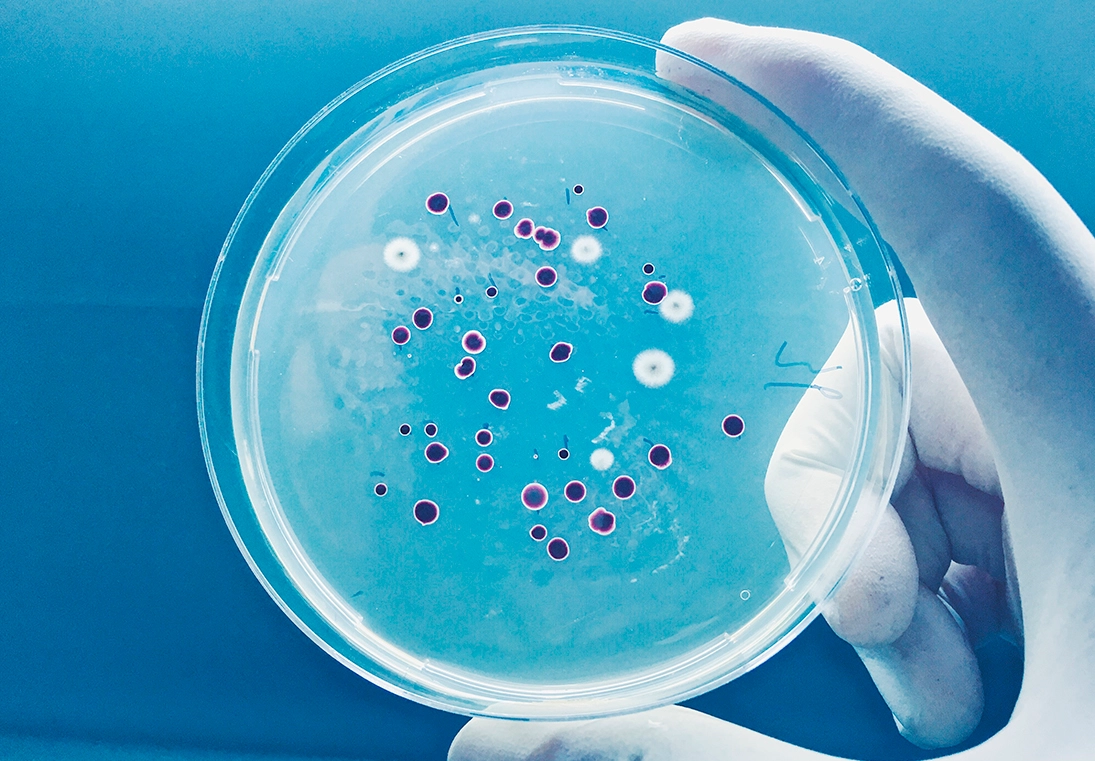
Quand les bactéries résistent aux antibiotiques

Quand les bactéries résistent aux antibiotiques
L’antibiorésistance constitue aujourd’hui l’une des plus graves menaces qui pèsent sur la santé mondiale. De plus en plus d’infections bactériennes deviennent difficiles à traiter car les médicaments perdent de leur efficacité. Chacun peut être touché, quel que soit son sexe, son âge ou son pays d’origine, et dans les trente prochaines années 2,4 millions de personnes en Europe, en Amérique du Nord et en Australie seraient menacées. Heureusement, la lutte s’organise pour ralentir ce phénomène.
Si les antibiotiques, qui ont la capacité de soigner les infections bactériennes, ont permis de réduire fortement la mortalité liée aux maladies infectieuses, ils ont aussi conduit à l’apparition de bactéries résistantes. L’utilisation massive et répétée de ces médicaments en est la cause. Ce phénomène global est devenu particulièrement préoccupant, au point que l’Organisation mondiale de la santé (OMS) alerte régulièrement la communauté internationale sur « l’usage excessif et inapproprié des antibiotiques qui nous met tous en danger ». Un rapport de l’Organisation de coopération et de développement économiques (OCDE), publié le 7 novembre 2018, confirme ces craintes : « Les infections à « superbactéries » pourraient tuer quelque 2,4 millions de personnes en Europe, en Amérique du Nord et en Australie au cours des trente prochaines années si l’on ne redouble pas d’efforts pour enrayer l’antibiorésistance. » Cette dernière a par ailleurs un coût très élevé pour les Etats. L’OCDE estime ainsi que « les complications engendrées par la résistance aux antimicrobiens pourraient coûter jusqu’à 3,5 milliards USD (dollars américains, NDLR) par an en moyenne ».
Une importante découverte médicale
Pour mieux comprendre la situation actuelle, il faut commencer par définir ce qu’est un antibiotique : « Il s’agit d’une molécule chimique, le plus souvent d’origine naturelle, qui peut être produite soit par une bactérie, soit par un champignon et qui tue les bactéries ou les empêche de se multiplier », explique Philippe Glaser, responsable de l’unité écologie et évolution de la résistance aux antibiotiques à l’Institut Pasteur. En 1928, le premier médicament de ce type, la pénicilline, a été identifié par Alexandre Fleming. Cette grande révolution médicale ne sera exploitée à grande échelle qu’à partir de la Seconde Guerre mondiale. L’industrie pharmaceutique investit alors massivement dans la recherche et découvre de nouvelles molécules. Cependant, dès les années 1970, le monde médical, alors qu’il était bien loin d’imaginer cela possible, se rend compte qu’il existe des résistances aux traitements.
La contre-attaque des bactéries
Les chercheurs découvrent qu’en présence de l’antibiotique, des bactéries dites sensibles sont éliminées alors que quelques-unes dites résistantes, parce qu’elles sont insensibles à l’action du médicament, prennent leur place et se multiplient. « C’est un processus darwinien de sélection, constate Philippe Glaser. Ce ne sont pas les espèces les plus fortes ou les plus intelligentes qui survivent, mais ce sont celles qui savent s’adapter au changement. Cette théorie s’applique parfaitement aux bactéries résistantes. » Deux mécanismes distincts coexistent : « Dans le premier cas, la bactérie mute et devient insensible ou imperméable à l’antibiotique, indique le spécialiste. Lorsqu’elle se réplique, elle transmet le gène de résistance à sa descendance. Dans le deuxième cas, la bactérie a acquis un gène de résistance qui fabrique une protéine détruisant l’antibiotique ou modifiant la cible sur laquelle il agit pour la rendre insensible. Elle peut, là encore, le transmettre à sa descendance, mais aussi à une autre bactérie, même si celle-ci est d’une espèce différente. »
Une mauvaise utilisation
La prolifération des bactéries résistantes est aisée et une personne infectée peut les transmettre rapidement à son entourage. Le milieu hospitalier est particulièrement à risque car des malades, à l’immunité souvent faible, s’y côtoient et de grandes quantités d’antibiotiques y sont prescrites. Par exemple, le très connu et inquiétant staphylocoque doré, qui peut entraîner une infection généralisée du sang, voire le décès, et contre lequel les traitements ne fonctionnent pas, peut s’y développer facilement. A cette problématique s’ajoute aussi celle de la consommation massive et inappropriée des antibiotiques. Ces derniers sont encore trop souvent utilisés pour traiter les angines alors même que 70 % d’entre elles sont d’origine virale. « Pourtant, dans ce cas, des tests simples et rapides existent », rappelle Philippe Glaser. Lorsqu’un patient est atteint par une infection bactérienne, « le médecin peut prescrire un diagnostic microbiologique avec un antibiogramme, qui identifiera à quels antibiotiques la bactérie est sensible ou résistante, poursuit-il. En attendant les résultats, il peut choisir un antibiotique à large spectre en première intention afin de ne pas laisser la personne sans solution médicale. Si celui-ci ne se révèle pas efficace, il pourra alors se reporter sur l’analyse faite par le laboratoire qui aura identifié la souche de la bactérie et adapter le traitement. » Face à un micro-organisme super-résistant, seul un antibiotique de dernier recours pourra agir. Mais, celui-ci ne pourra être délivré qu’à l’hôpital ou en clinique, dans un cadre extrêmement contrôlé. « Nous devons conserver nos munitions pour éviter de développer la résistance », confie le spécialiste de l’Institut Pasteur.
Un impact sur les hommes, les animaux et l’environnement
La question de la lutte contre l’antibiorésistance concerne à la fois la santé humaine, la santé animale et celle des écosystèmes : tous sont interconnectés. Par ses multiples interactions avec l’environnement, l’activité humaine contribue à diffuser les résistances, notamment dans l’eau qui vient à son tour polluer le sol et les cultures qui y sont faites. L’élevage a aussi sa part de responsabilité. Les bactéries résistantes peuvent être présentes dans la viande et contaminer l’homme qui ensuite les transmet à son animal de compagnie. Pour mettre fin à ce cercle vicieux, l’OMS préconise de mettre en place une approche de lutte globale intitulée One world, one health (Un monde, une santé). Pour obtenir des résultats, « de nombreux professionnels aux compétences multiples, actifs dans différents secteurs tels que la santé publique, la santé animale, la santé végétale et l’environnement, doivent unir leurs forces », affirme l’organisation.
Un problème mondial de santé publique
En 2014 déjà, l’OMS avait publié un rapport alarmant, qui avait marqué les esprits, sur l’émergence de l’antibiorésistance et sur le manque de données dans les pays en voie de développement. La résistance n’a en effet pas de frontières. Le tourisme médical, les migrations ou les mouvements de population lors de conflits contribuent à la propagation des micro-organismes d’un bout à l’autre de la planète. Face à ce constat, le Plan d’action mondial pour combattre la résistance aux antimicrobiens a été adopté en mai 2015 par l’Assemblée mondiale de la santé. Celui-ci définit cinq objectifs : « mieux faire connaître et comprendre le problème de la résistance aux antimicrobiens ; renforcer les connaissances et les bases factuelles par la surveillance et la recherche ; réduire l’incidence des infections ; optimiser l’usage des agents antimicrobiens ; garantir des investissements durables pour combattre la résistance aux antimicrobiens ». En juin 2017, la Commission européenne s’est à son tour dotée d’un Plan d’action qui comporte trois axes : « faire de l’Union européenne une région de pratiques d’excellence, encourager la recherche, le développement et l’innovation en matière de résistance aux antimicrobiens et donner corps aux objectifs mondiaux ». La France a quant à elle lancé, en novembre 2016, un programme interministériel de maîtrise de l’antibiorésistance qui a pour but de « mieux sensibiliser le public, mieux utiliser les antibiotiques, davantage soutenir la recherche et l’innovation et, enfin, renforcer la surveillance et l’engagement de la France dans la lutte internationale contre l’antibiorésistance ».
Réduire et cibler la consommation
Pour préserver le plus longtemps possible l’efficacité des antibiotiques, il est nécessaire d’avoir une consommation raisonnée. Les campagnes nationales de prévention martèlent ce message et c’est également le cas de la dernière en date, lancée en novembre 2018, dont le slogan est « Ils sont précieux, utilisons-les mieux ». Pour accompagner le changement, les médecins sont particulièrement sollicités. Ils sont encouragés à utiliser tous les moyens dont ils disposent (tests de dépistages, antibiogrammes…) pour adapter la cure aux besoins du malade. Le grand public peut lui aussi agir à son niveau en prenant quelques précautions (lire l’encadré « Des conseils simples de prévention »). Du côté du monde animal, les progrès sont en cours. Le plan Ecoantibio a d’ores et déjà permis la réduction de 39 % de l’utilisation d’antibiotiques vétérinaires en six ans, toutes filières confondues. Le ministère de l’Agriculture et de l’Alimentation espère poursuivre cet effort jusqu’en 2021, date de fin du plan. Pour cela, il continue de communiquer autour du message « Les antibios, comme il faut, quand il faut ».
Les enjeux de la recherche
En parallèle des mesures préventives, la lutte contre l’antibiorésistance doit également concerner la recherche. « En plus de la surveillance de la résistance et des travaux pour comprendre le fonctionnement des bactéries, les chercheurs doivent développer de nouvelles molécules », souligne Philippe Glaser avant d’ajouter : « mais, le marché des antibiotiques est beaucoup moins rentable que celui des médicaments contre les affections chroniques. » D’autres voies thérapeutiques sont aussi explorées à l’image de la phagothérapie. « Elle consiste à administrer des phages, des virus qui infectent et tuent spécifiquement certaines bactéries, précise le spécialiste. Ils permettent d’éliminer les bactéries pathogènes sans affecter les autres, contrairement aux antibiotiques à spectre large. » Autre piste : développer de nouveaux vaccins. « En évitant les maladies bactériennes, on peut ainsi réduire davantage le développement des résistances »,observe-t-il. L’espoir est donc permis à condition de continuer d’être attentif à nos usages afin de mener le combat au long cours de la lutte contre l’antibiorésistance.
Des conseils simples de prévention
Il est possible, chacun à son niveau, de prévenir et combattre la propagation de la résistance aux antibiotiques. L’Organisation mondiale de la santé (OMS) a émis une liste de recommandations facile à appliquer :
-
- n’utiliser les antibiotiques que s’ils sont prescrits par un professionnel de santé qualifié ;
-
- ne jamais en exiger si le médecin estime qu’ils ne sont pas nécessaires ;
-
- toujours respecter les conseils du soignant (posologie, durée…) ;
-
- ne jamais partager les antibiotiques avec d’autres personnes ou utiliser ceux qui restent d’un précédent traitement ;
-
- prévenir les infections en se lavant régulièrement les mains, en évitant les contacts proches avec des malades, en ayant des rapports sexuels protégés et en tenant ses vaccinations à jour ;
-
- préparer ses repas en respectant les règles d’hygiène (séparer les aliments crus et cuits, bien les laver et bien les cuire, les conserver à une température adaptée) et choisir des produits, d’élevage notamment, sans antibiotiques.
Quelques chiffres
En France, l’antibiorésistance est à l’origine de 125 000 infections chaque année et de 5 500 décès (700 000 dans le monde).En 2017, 759 tonnes d’antibiotiques destinés à la santé humaine ont été vendues en France. 93 % de ces médicaments ont été utilisés en médecine de ville et 7 % en établissements de santé.
Cette même année, les ventes d’antibiotiques pour la santé animale ont atteint 499 tonnes, dont 95 % ont été administrés à des animaux destinés à la consommation humaine et 5 % à des animaux de compagnie.
Les Français prennent 35 % d’antibiotiques en plus que leurs voisins européens. Par rapport aux Hollandais, par exemple, leur consommation est trois fois supérieure.
Source : Santé publique France.
• Antibiotiques.gouv.fr, le site du ministère des Solidarités et de la Santé.
• Who.int/fr, le site de l’Organisation mondiale de la santé (OMS) et plus particulièrement la page dédiée au thème « Résistance aux antimicrobiens ».


